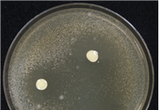

-

공정위, 설 명절 앞두고 ‘불공정 하도급 신고센터’ 운영
- 2017-12-26 10:43
- 백혜린
-

1조 917억원 R&D 자금, 일자리 창출 기업에 투입!
- 2017-12-26 10:23
- 백혜린
-

겨울철 ‘성에, 결로’ 걱정없는 차량 유리 연구활발
- 2017-12-26 09:22
- 백혜린
-

4차 산업혁명시대 황금알을 낳는 '웹툰산업' 큰 주목
- 2017-12-26 09:19
- 백혜린
-

혁신성장을 견인하고, 4차 산업혁명 대응을 선도할 구체적인 범부처 성장동력 분야 확정
- 2017-12-26 09:17
- 백혜린
-

주한미군 관련 범죄피해자 보호·지원에 관한 업무협약 체결
- 2017-12-22 16:21
- 백혜린
-

“반도체장비 수리 설비 국산화를 통해 비용 1/3수준으로 절감”
- 2017-12-22 15:35
- 백혜린
-

2018년 원/위안 직거래시장 시장조성자 선정
- 2017-12-22 15:31
- 백혜린
-

2017년 국민이 공감하는 최고의 기획재정부 정책 '통화스와프 확대'
- 2017-12-22 15:27
- 백혜린
-

소공인 지원정책, 변화와 혁신의 길을 묻다!
- 2017-12-22 15:24
- 백혜린
-

하도급지킴이 이용 실적 전년 대비 67% ‘증가’
- 2017-12-22 15:11
- 백혜린
-

(사)한국액셀러레이터협회 창립식 개최
- 2017-12-22 14:56
- 백혜린
-

러시아 하바롭스크로 가는 하늘길, 더욱 넓어진다.
- 2017-12-22 14:52
- 백혜린
-

3분기 건설공사 계약액, 전년 같은 기간 대비 소폭 하락
- 2017-12-22 14:50
- 백혜린
-

법제처, 미국 법제기관과 법제 교류 강화 모색
- 2017-12-22 14:39
- 백혜린
-

해외조달시장 진출 유망기업 지정 ‘확대’
- 2017-12-22 14:20
- 백혜린
-

에어로케이, 플라이양양 항공운송사업 면허신청 반려 결정
- 2017-12-22 11:53
- 백혜린
-

미생물 균주 섞어 보존성·소화율 높인 사일리지 만든다
- 2017-12-22 10:41
- 백혜린
-

다단계판매업자·후원방문판매업자의 정보공개에 관한 고시 개정·시행
- 2017-12-22 10:20
- 백혜린
-

국방 사이버 댓글사건 조사TF, 조사활동 기한 연장
- 2017-12-22 10:18
- 백혜린
-

신용관리 체험사례 공모전을 통해 살펴본 신용관리 10대 요령
- 2017-12-22 09:47
- 백혜린
-

“중소벤처기업의 성장과 도약, 금융이 함께 합니다”
- 2017-12-22 09:41
- 백혜린
-

방위산업기술 보호 업무, 어렵지 않아요
- 2017-12-22 09:38
- 백혜린
-

한-베트남 외교장관회담 결과
- 2017-12-21 16:58
- 백혜린
- 1 [기고] “ 안양에서 살아 행복합니다, 그 말이 울려 퍼지는 도시를 위하여 ”
- 2 "한식 세계화 위해 지혜 모으자"…재외동포청 차장, 글로벌 한식포럼서 강조
- 3 안성시, 축산냄새 저감 성과공유회 개최
- 4 광주광역시체육회, 제106회 전국체전 양궁 2관왕 오예진 (3일차)
- 5 의정부공업고,“미래역량강화 교과연계 학생 연수”실시
- 6 섬꽃 전국마라톤대회, 10월 12일 개최...거제면 일부 구간 전면 도로통제
- 7 성남시의회 정용한 의원, 시유지 매각과 ‘잊혀질 권리’ 문제 제기
- 8 시장과 시민이 만났다… ‘안성시 복지이야기 한마당’ 성황리 종료
- 9 아름다운 호수공원에서 펼쳐지는 빛의 향연 '2025 화성 루나 빛 축제' 10월 25일 동탄호수공원에서 개최
- 10 ‘2025 송정벚꽃야간음식문화페스타’, 송정벚꽃골목에서 만나는 가을 축제...10월 25일 개최
- 경기도소식"혼자가 아니예요" 시흥시보건소, 홀몸 어르신 대상 건강·소통 프로그램 운영
- 교육/문화시흥시 "연꽃테마파크서 곤충 잡고, 연근 캐볼까?" '가족과 함께하는 연근캐기 행사' 10월 25일 개최
- 정치/사회시흥시, 거북섬에서 '건강해로(海路) 걷기교실·별빛운동교실' 운영 … 가을밤 건강 챙겨요
- 연예/스포츠‘김창옥쇼4’ 김창옥 & 황제성, 시청자의 ‘귀’가 되어 드리겠습니다! 티저 영상 공개
- 체험활동너무 덥다고? 나와서 즐겨~! '2022 김포 해양레저스포츠 체험교실' 함께해요
- 핫뉴스김광열 영덕군수, 군민 속으로… “현장에서 답을 찾고 미래를 그린다”
- 환경농식품부, 2025/2026년 겨울철 가축전염병 특별방역대책 추진